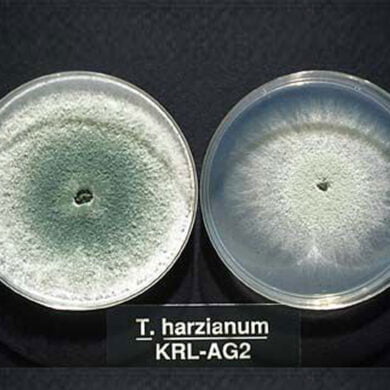

بحوث الدكتور ابراهيم الجبوري
- بحوث منفردة

الحساسية النسبية لبعض أصناف القطن الموصى بزراعتها في العراق للاصابة بدودة جوز القطن الشوكية (Lepidoptera : Noctuidae ) Earias insulana Boisd وتأثيرهما في الاداء الحياتي للآفة
الحساسية النسبية لبعض أصناف القطن الموصى بزراعتها في العراق
أكمل القراءة » - بحوث منفردة

استخدام الإختبار الحيوي لتحديد كفاءة مجموعة مختارة من مبيدات ضد اناث الحلم ذي البقعتين Tetranychus urticae على نبات القطن
استخدام الإختبار الحيوي لتحديد كفاءة مجموعة مختارة من مبيدات
أكمل القراءة » - بحوث منفردة

الأداء الحياتي لحشرة دودة الخروع Phycita diaphana تحت ظروف المختبر والحقل
الأداء الحياتي لحشرة دودة الخروع Phycita diaphana تحت ظروف ا
أكمل القراءة » - بحوث منفردة

الكثافة السكانية والتجميع الحراري لحشرة دودة الخروع Phycita diaphana Stgr. (Lepidoptera:Pyralidae)
الكثافة السكانية والتجميع الحراري لحشرة دودة الخروع Phycita
أكمل القراءة » - بحوث منفردة

خصائص صفة مقاومة الحلم العنكبوتي ذو البقعتين T. urticae لمبيد Bromopropylate
خصائص صفة مقاومة الحلم العنكبوتي ذو البقعتين T. urticae لمبي
أكمل القراءة » - بحوث منفردة

تأثير مثبط النمو الحشري ماتش في حفار ساق الذرة تحت ظروف المختبر والحقل
تأثير مثبط النمو الحشري ماتش في حفار ساق الذرة تحت ظروف المخ
أكمل القراءة » - بحوث منفردة

التفضيل العائلي للعدو الطبيعي Trichogramma embryophagum المتطفل على بيوض نوعين من جنس Ephestia
التفضيل العائلي للعدو الطبيعي Trichogramma embryophagum المت
أكمل القراءة » - بحوث منفردة

تسجيل جديد لنيماتودا متطفلة على الحشرات في العراق
تسجيل جديد لنيماتودا متطفلة على الحشرات في العراق. مجلة وقاي
أكمل القراءة » - بحوث منفردة

تأثير معاملات الرش المتتابع والمتبادل في تطوير مقاومة الحلمة ذات البقعتين Tetranychus urticae (Koch) لمبيد Bromopropylate حقلياً
تأثير معاملات الرش المتتابع والمتبادل في تطوير مقاومة الحلمة
أكمل القراءة » - بحوث منفردة

تاثير درجات الحرارة المختلفة في حياتية الحلم ذي الرسغ الشعري Polyphagotarsonemus latus على البطاطس تحت الظروف المختبرية
تاثير درجات الحرارة المختلفة في حياتية الحلم ذي الرسغ الشعري
أكمل القراءة » - بحوث منفردة

التسجيل الأول لدبور تورم الأوراق (Ophelimus maskelli (Ashmeadعلى شجر اليوكالبتوس Eucalyptus camaldulensis في كربلاء، العراق
التسجيل الأول لدبور تورم الأوراق (Ophelimus maskelli (Ashmea
أكمل القراءة » - بحوث منفردة

التاثير الحيوي لزيت بذور الحنظل Citrullus colocymthis L. على الاطوار المختلفة للحلم العنكبوتي ذي البقعتين Tetranychus urticae Koch
التاثير الحيوي لزيت بذور الحنظل Citrullus colocymthis L. على
أكمل القراءة » - بحوث منفردة

حياتية ومكافحة البقة المبرقشة على نبات السلجم Bagrada hilaris (Burm)
حياتية ومكافحة البقة المبرقشة على نبات السلجم Bagrada hilari
أكمل القراءة » - بحوث منفردة

التقييم المختبري لفاعلية عزلتين محليتين من الفطر Beauveria bassiana (Blas.) Vuil على يرقات دودة ثمار التفاح Cydia pomonella (L.)
التقييم المختبري لفاعلية عزلتين محليتين من الفطر Beauveria b
أكمل القراءة » - بحوث منفردة

تأثير درجات الحرارة المختلفة على حياتية حشرة حفار أوراق الطماطة (Diptera : Agromyzidae)Liriomyza bryoniae (Kalt.)
تأثير درجات الحرارة المختلفة على حياتية حشرة حفار أوراق الطم
أكمل القراءة »
- 1
- 2